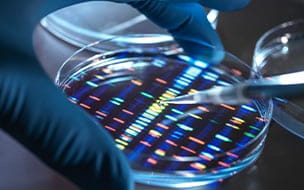

Sakti Chakrabarti, MD
- Specialty: Hematology and Oncology
-
Primary Location: 11100 Euclid Ave (0 mi.)
Other Locations - Languages Spoken: English
Office Locations
UH Seidman Mentor Health Center (20 mi.)
9485 Mentor Ave
Ste 3
Mentor, OH 44060
440-205-5755
Biography: Sakti Chakrabarti, MD
Certifications & Memberships
- Medical Oncology - American Board of Internal Medicine
Education
Fellowship | Advanced GI Oncology
Advanced GI Oncology - Mayo Clinic (2017 - 2019)
Fellowship | Hematology/Oncology
Hematology/Oncology - National Heart, Lung, And Blood Institute (2001 - 2004)
Residency | Internal Medicine
Internal Medicine - University Of Connecticut Health Center (1999 - 2001)
Medical Education
University Of Calcutta (1992)
Patient Experience Reviews
Dr C was very nice to my mom. He noted her ill appearance and was concerned. He ordered fluids and bloodwork immediately. I appreciated him taking action due to his concerns and looking out for my mom's best interest.
EXCELLENT
Excellent
I highly recommend University Hospitals.
All good.
Good experience
Very good by far .
I really enjoyed being at this office, everyone was exceptionally friendly and helpful, I'm glad that I went to this office!!!
LOVE Dr Chakrabarti. He has saved my life. He is so smart and has an excellent bedside manner.
Excellent, he is one of the best Doctors I've ever dealt with.
Excellent care and concern!
Very good, by far Confident about my provider medical knowledge, and appreciative of the personal care from the entire team.
Excellent
Overall my experience is always great.
Related Blog Articles
Lynch Syndrome: Genetic Disorder Raises Risk of Many Cancers
A family history of Lynch syndrome-associated cancers is an important reason to get genetic testing for the disorder.

Retired Truck Driver Chooses Groundbreaking Cancer Care at UH
After Brian Weary was diagnosed with colorectal cancer, he underwent lifesaving immunotherapy treatments at UH to erase his cancer.
Industry Relationships
University Hospitals is committed to transparency in our interactions with industry partners, such as pharmaceutical, biotech, or medical device companies. At UH, we disclose practitioner and their family members’ ownership and intellectual property rights that are or in the process of being commercialized. In addition, we disclose payments to employed practitioners of $5,000 or more from companies with which the practitioners interact as part of their professional activities. These practitioner-industry relationships assist in developing new drugs, devices and therapies and in providing medical education aimed at improving quality of care and enhancing clinical outcomes. At the same time, UH understands that these relationships may create a conflict of interest. In providing this information, UH desires to assist patients in talking with their practitioners about industry relationships and how those relationships may impact their medical care.
UH practitioners seek advance approval for certain new industry relationships. In addition, practitioners report their industry relationships and activities, as well as those of their immediate family members, to the UH Office of Outside Interests annually. We review these reports and implement management plans, as appropriate, to address conflicts of interest that may arise in connection with medical research, clinical care and purchasing decisions.
View UH’s policy (PDF) on practitioner-industry relationships.
As of December 31, 2016, Sakti Chakrabarti did not disclose any Outside Relationships with Industry.